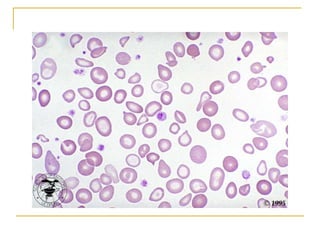
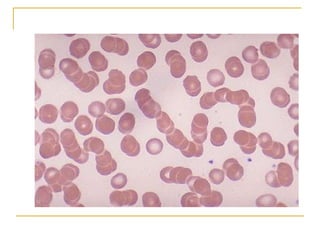
rouleaux
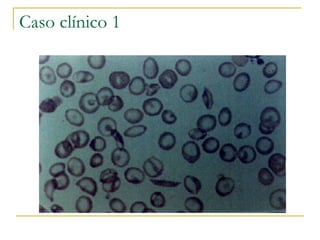
Caso clínico 1
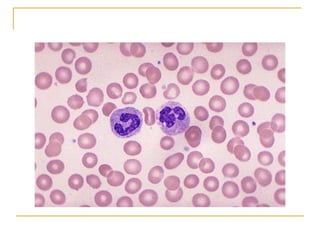
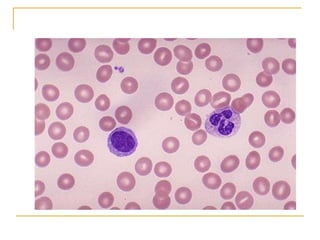
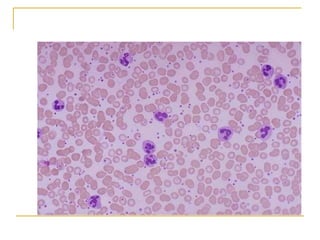
neutrofilia

O documento descreve os componentes e procedimentos de um hemograma. Um hemograma inclui um eritrograma, leucograma e contagem de plaquetas. O eritrograma mede os eritrócitos, hematócrito, hemoglobina e analisa o esfregaço sanguíneo. O leucograma inclui a contagem e diferencial de leucócitos.